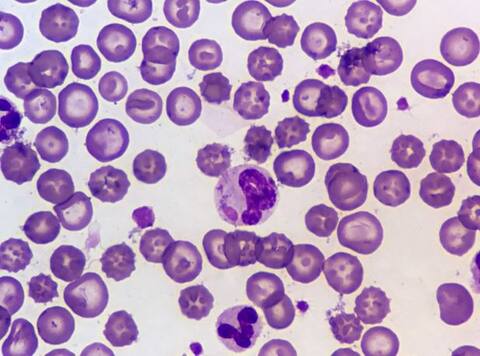
Nipah Virus के बारे में ये बातें जानना है बेहद जरूरी

- होम
- फोटो गैलरी / न्यूज़
- Nipah Virus के बारे में ये बातें जानना है बेहद जरूरी
Nipah Virus के बारे में ये बातें जानना है बेहद जरूरी


ये एक्सपर्ट के दावे पर हैं. ABP न्यूज़ इसकी पुष्टि नहीं करता. आप किसी भी सुझाव पर अमल या इलाज शुरू करने से पहले अपने एक्सपर्ट की सलाह जरूर ले लें.फोटोः गूगल फ्री इमेज

निपाह वायरस दुनिया के सबसे खतरनाक वायरस में से एक है जिससे कई घातक बीमारियां तक हो सकती हैं.फोटोः गूगल फ्री इमेज

निपाह वायरस में H1N1 वायरस की तरह बदलने की प्रवृत्ति है. उदाहरण के तौर पर अगर इस साल आप स्वाइन फ्लू या इंफ्लूएंजा वैक्सीनेशन लेते हैं तो इस टीके का प्रभाव अगले साल तक नहीं होगा. क्योंकि अगले साल तक वायरल का स्वरूप बदल जाएगा. इसी वजह से ये जानलेवा वायरस है.फोटोः गूगल फ्री इमेज
इस बार निपाह वायरस के दौरान इंसानों से इंसानों में फैलने के मामले भी सामने आए हैं. ऐसे में इस पर रिसर्च की जा रही है कि ये कैसे फैल रहा है. क्या ये इंफेक्टिेड व्यक्ति के संपर्क में आने से ऐसा हो रहा है? या फिर इंफेक्टिड व्यक्ति को जिस सोर्स के जरिए ये इंफेक्शन हुआ है उसकी वजह से ये बीमारी फैल रही है?फोटोः गूगल फ्री इमेज

जूनोटिक बीमारियों के दौरान यदि वायरस से ग्रसित जानवर को उचित एंटीबायोटिक्स दे दी जाएं तो इंसानों में इस बीमारी के फैलने के खतरे को कम किया जा सकता है.फोटोः गूगल फ्री इमेज

Nipah virus इंफेक्शन जूनोटिक डिजीज का बेहतर उदाहरण है. जहां जानवरों में होने वाली बीमारियों इंसानों में ट्रांसफर हो जाती हैं.फोटोः गूगल फ्री इमेज

निपाह वायरस दिमाग को प्रभावित करता है. निपाह वायरस से ग्रसित व्यक्ति को बुखार, शरीर में कमजोरी और सुस्ती रहती है.फोटोः गूगल फ्री इमेज

निपाह वायरस दुनियाभर में जहां भी रिपोर्ट हुआ है इससे 75 से 100 प्रतिशत तक मृत्यु होने की रिपोर्ट भी दर्ज हुई है.फोटोः गूगल फ्री इमेज
रिलेटेड फ़ोटो

दुनिया में कहां हैं सबसे ज्यादा हवाई अड्डे, टॉप-10 में कौन से देश? जानें किस नंबर पर है भारत
असम की ब्लैक टी, कश्मीरी केसर से लेकर बंगाल का सिल्वर सेट तक... PM मोदी ने पुतिन को दिए ये गिफ्ट, PHOTOS

हाथ मिलाया, गले मिले और फिर एक ही गाड़ी में रवाना... मोदी-पुतिन की दोस्ती देख चीन-PAK के उड़े होश, ट्रंप को भी टेंशन!

बाढ़ से त्रस्त श्रीलंका की मदद के लिए आगे आया भारत, दरियादिली दिखाते हुए भेजी 12 टन राहत सामग्री, देखें तस्वीरें

राम मंदिर के शिखर पर पीएम मोदी ने फहराया धर्म ध्वज! देखें शानदार तस्वीरें

टॉप स्टोरीज
UP विधानसभा चुनाव को लेकर स्वामी अविमुक्तेश्वरानंद का बड़ा ऐलान, बोले- 'सभी 403 सीटों पर...'

ISI के निशाने पर केंद्रीय कृषि मंत्री शिवराज सिंह चौहान, खतरे को देखते हुए सुरक्षा बढ़ाई, Z+ सिक्योरिटी मिली हुई

IPL 2026 की नीलामी में इन 10 विदेशी खिलाड़ियों पर रहेंगी नजरें, 3 को मिल सकते हैं 10 करोड़ से ज्यादा

Year Ender 2025: इन 6 फिल्मों की रिलीज से पहले बना था खूब बज, आते ही फुस्स हो गईं सभी







